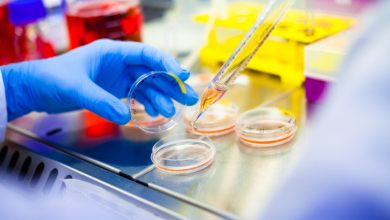

إقليم بولمان: عملية التلقيح ضد كوفيد 19 تمر في ظروف جيدة، وبتعبئة كبيرة من طرف الأطر الطبية والسلطات المحلية
كاظم بوطيب
تمر الحملة الوطنية للتلقيح ضد كوفيد -19 على مستوى إقليم بولمان في ظروف جيدة، بمشاركة كافة المتدخلين، وانخراط قوي للمواطنين المعنيين بهذه العملية.
وأبانت السلطات المحلية والصحية والأمنية بالإقليم وكذا جميع المتدخلين عن تعبئة قوية لإنجاح هذه العملية التي أعطى انطلاقتها صاحب الجلالة الملك محمد السادس في متم يناير الماضي، والتي تعرف مشاركة مكثفة للفئات المستهدفة.
وأفاد مسؤولو الصحة بالإقليم أنه تمت، في المجمل، تعبئة عدد كبير من مراكز التلقيح على مستوى إقليم بولمان، منها ما ثم توفيره بالوسط الحضري ومنها ما ثم تجهيزه من مركز بالوسط القروي.
وأكد المندوب الإقليمي للصحة، الدكتور الحسين أبو الفضل ، في تصريح صحفي، أن حملة التلقيح هاته سبقتها تحضيرات مكثفة واجتماعات متوالية مع أطر الصحة وجميع المتدخلين، لاسيما السلطة المحلية برئاسة عامل الإقليم، ودلك في إطار لجنة اليقظة.
وأضاف أن الأسابيع الأولى من الحملة همت الفئات العاملة في الصفوف الأمامية لمواجهة الجائحة، والمتمثلة في العاملين بقطاع الصحة الذين يفوق سنهم 40 سنة، والسلطات الأمنية، وأطر التعليم البالغين 45 سنة فما فوق، بالإضافة إلى الأشخاص الذين يتجاوز سنهم 75 سنة.
وأكد ذات المسؤول أننا “شرعنا في الأسابيع الأخيرة في توسيع عملية التلقيح لتشمل الأشخاص البالغين 60 سنة فما فوق، وتعرف هذه المرحلة، على غرار المرحلة الأولى، انخراطا قويا للمواطنين. وتمر العملية بشكل سلس وفي احترام تام لتدابير السلامة الصحية”.
وأشار نفس المسؤول إلى أنه لم يتم تسجيل أي مضاعفات صحية مرتبطة بالتلقيح، باستثناء بعض الآثار الجانبية البسيطة التي تزول في غضون 48 ساعة.
وأعرب السيد أبو الفضل عن امتنانه لجميع المتدخلين لاسيما الأطر الصحية الذين يبذلون جهودا كبيرة وأبانوا عن حس عال من التفاني والتضحية، وكذا السلطات الإقليمية والمحلية وعلى رأسها السيد عبد الحق الحمداوي عامل الإقليم ،والسيد سعيد الدبيش باشا المدينة، والسيد حسام التكموتي قائد الملحقة الادارية الأولى، والسيدة حورية الفرقان قائدة الملحقة الإدارية الثانية، وجميع أعوان السلطة وكل الشركاء والمتدخلين ومن بينهم الهلال الأحمر المغربي وجمعيات المجتمع المدني.
من جهة أخرى، تدعو السلطات الصحية الإقليمية المواطنين إلى الانخراط المكثف في حملة التلقيح هاته التي تشكل السبيل الوحيد للخروج من الجائحة، مؤكدة على ضرورة مواصلة احترام التدابير الوقائية والاحترازية الصحية، لاسيما ارتداء الكمامات الواقية، والتباعد الاجتماعي، وذلك قبل وأثناء وبعد التلقيح، بهدف من أجل تحقيق المناعة الفردية والجماعية.
وعلى مستوى مدينة ميسور وبمركز “دار الشباب” ولحد كتابة هده السطور بلغ عدد المستفيدين من عملية التلقيح في المرحلة الأولى ممن تلقوا الجرعة الأولى حوالي3935 مستفيد ، في حين استفاد حوالي 3490 شخص من الجرعة الثانية ، وكلهم من الفئات المستهدفة البالغة 60 سنة فما فوق.
و تمر عملية التقليح ضد كوفيد 19 بإقليم بولمان في ظروف جيدة وفي تنظيم محكم وفق البروتوكول المحدد .وأشاد السيد سعيد الدبيش باشا مدينة ميسور بانخراط كل مكونات السلطات المحلية و الأطر الصحية والطبية التي تسهر على هذه العملية، وكذا السلطات الإقليمية لبولمان ٬ ودعا المواطنين إلى ضرورة الالتزام بأخذ الجرعة الثانية من اللقاح في الموعد المحدد لها لكونها ضرورية للحصول على مناعة كاملة ضد الفيروس .
كادم بوطيب